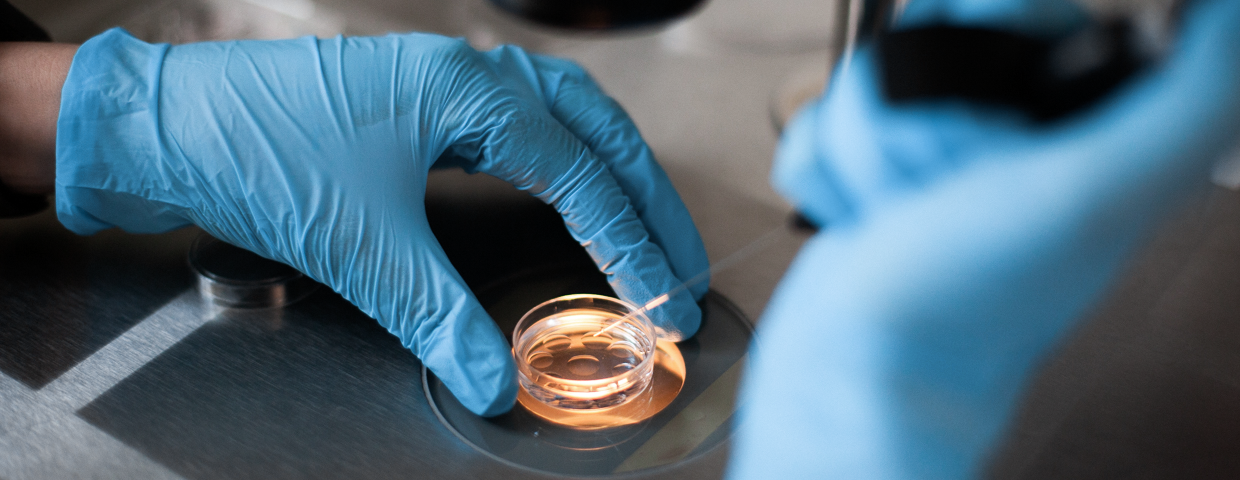

Этот вопрос очень часто звучит от наших потенциальных доноров, поэтому сегодня мы расскажем обо всех нюансах.
Начнем с того, что все доноры ооцитов в нашем каталоге стали донорами именно после родов. Для женщин-доноров в ADAM & EVA SPERM AND EGG BANK есть один важный критерий – наличие ребенка. Также не забывайте и о возрастных ограничениях, в нашем банке донорами ооцитов могут стать только женщины в возрасте от 18 до 32 лет.
Когда после родов можно стать донором яйцеклеток?
Минимальный срок, который должен пройти от момента родов до вступления в программу донорства – 6 месяцев. Но здесь есть еще один важный нюанс – грудное вскармливание. Пока Вы кормите малыша грудью, Вы не можете быть донором, поэтому мы советуем планировать программу сразу после завершения грудного вскармливания и полного восстановления менструального цикла
Если же малыш находится на искусственном вскармливании, то Вы можете вступать в программу уже через полгода после родов, при условии восстановления менструального цикла. Но не забывайте, что перед началом программы донорства Вас ждет всестороннее медицинское обследование. Чтобы гарантировать Клиентам высокое качество донорского материала, мы тщательно обследуем наших доноров, в том числе и на генетику.